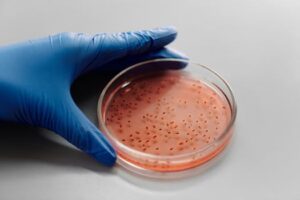

⏱️ 7 min read
The human body is an extraordinary biological machine that continues to fascinate scientists and medical professionals around the world. Despite centuries of research and study, this complex system still holds countless mysteries and surprising capabilities. From the microscopic level of cellular activity to the coordinated functions of entire organ systems, our bodies perform remarkable feats every single day without us even realizing it. The following facts reveal some of the most intriguing and unexpected aspects of human anatomy and physiology that demonstrate just how amazing our bodies truly are.
Fascinating Discoveries About Our Physical Form
1. The Brain's Astounding Electrical Activity
The human brain generates enough electrical power to light up a small LED bulb. With approximately 86 billion neurons firing simultaneously, the brain produces between 12-25 watts of electricity when awake. These electrical impulses travel at speeds up to 268 miles per hour, allowing for split-second reactions and complex thought processes. This incredible electrical network enables everything from basic motor functions to abstract reasoning, making the brain one of the most energy-intensive organs relative to its size. The brain uses about 20% of the body's total oxygen supply despite comprising only 2% of total body weight.
2. The Stomach's Powerful Digestive Acid
The hydrochloric acid in the human stomach is remarkably potent, with a pH level between 1.5 and 3.5. This acid is strong enough to dissolve metal, including razor blades and nails, given enough time. To protect itself from this corrosive substance, the stomach produces a new mucus layer every two weeks, creating a protective barrier that prevents the acid from eating through the stomach wall. This regenerative capability is essential for survival, as without this protective mechanism, the stomach would literally digest itself. The stomach completely replaces its lining approximately every three to four days.
3. The Incredible Length of Blood Vessels
If all the blood vessels in an adult human body were laid end to end, they would stretch approximately 60,000 to 100,000 miles. This staggering distance is enough to circle the Earth more than twice at the equator. This extensive network includes arteries, veins, and capillaries that work together to deliver oxygen and nutrients to every cell in the body while removing waste products. The smallest blood vessels, capillaries, are so narrow that red blood cells must travel through them in single file. This vast circulatory highway ensures that even the most remote cells receive the resources they need to function properly.
4. The Eye's Superior Resolution Capabilities
Human eyes possess extraordinary resolution capabilities, with each eye containing approximately 130 million photoreceptor cells. If the eye were a digital camera, it would have a resolution of about 576 megapixels. The eyes can distinguish between approximately 10 million different colors and can detect a single photon of light in complete darkness. Furthermore, the focusing muscles in the eyes move around 100,000 times per day, making them the most active muscles in the entire body. The eye can also process 36,000 bits of information every single hour, making vision the dominant sense for most humans.
5. The Bone's Superior Strength-to-Weight Ratio
Human bones are remarkably strong for their weight, with bone tissue being roughly four times stronger than concrete in terms of compression strength. A cubic inch of bone can theoretically bear a load of 19,000 pounds, which is approximately the weight of five standard pickup trucks. Despite this incredible strength, bones remain lightweight due to their porous internal structure. The femur, or thighbone, is the longest and strongest bone in the body and can support up to 30 times the weight of an average adult's body mass. Bones are also dynamic organs that continuously remodel themselves throughout life, completely regenerating every seven to ten years.
6. The Nose's Remarkable Scent Detection
The human nose can detect and distinguish between approximately one trillion different scents, far exceeding previous estimates of just 10,000 odors. This incredible olfactory capability rivals that of many animals known for their superior sense of smell. The nose contains approximately 400 different types of scent receptors, and these receptors send signals directly to the brain's limbic system, which is why smells can trigger powerful memories and emotions instantly. Additionally, humans can detect certain substances in incredibly minute quantities—for instance, we can detect mercaptan, the odorant added to natural gas, at concentrations as low as one part per billion.
7. The Skin's Constant Renewal Process
Human skin completely renews itself approximately every 28 days, shedding between 30,000 and 40,000 dead skin cells every single minute. This means that over the course of a lifetime, the average person will shed approximately 105 pounds of dead skin. The skin is the body's largest organ, covering an average surface area of about 20 square feet in adults. It serves as the first line of defense against pathogens, regulates body temperature, and contains millions of nerve endings that provide the sense of touch. The skin also produces vitamin D when exposed to sunlight, making it an essential organ for bone health and immune function.
8. The Heart's Lifelong Endurance
The human heart beats approximately 100,000 times per day, pumping about 2,000 gallons of blood through the circulatory system daily. Over the course of an average lifetime of 75 years, the heart will beat more than 2.5 billion times without ever taking a break for rest. This tireless muscle generates enough pressure to squirt blood a distance of 30 feet when pumping at full capacity. The heart begins beating at approximately 21 days after conception and doesn't stop until death. Despite weighing only about 10 ounces on average, this remarkable organ works continuously to sustain life, adapting its rhythm to the body's changing needs throughout each day.
9. The Liver's Impressive Regenerative Powers
The liver is the only internal organ capable of complete regeneration from as little as 25% of its original tissue. This remarkable ability allows the liver to recover from injury, disease, or surgical removal of portions of the organ. The liver can regrow to its full size within a matter of weeks, making it unique among human organs. This regenerative capacity is essential given the liver's critical role in performing over 500 different functions, including detoxification, protein synthesis, and production of biochemicals necessary for digestion. The liver processes approximately 1.4 liters of blood every minute, filtering out toxins and metabolizing nutrients from everything we consume.
10. The Lungs' Vast Surface Area
The internal surface area of the lungs is surprisingly expansive, approximately equal to the size of a tennis court when spread out flat. This massive surface area is created by approximately 300 million tiny air sacs called alveoli, which facilitate the exchange of oxygen and carbon dioxide. An average person breathes about 20,000 times per day, inhaling roughly 2,600 gallons of air. The right lung is slightly larger than the left lung to accommodate the heart's position. The lungs also possess remarkable cleaning capabilities, with tiny hair-like structures called cilia beating about 1,000 times per minute to sweep mucus and debris out of the respiratory system.
Understanding Our Biological Complexity
These ten remarkable facts barely scratch the surface of the human body's incredible complexity and capabilities. From the brain's electrical activity to the lungs' vast surface area, each system demonstrates sophisticated biological engineering refined over millions of years of evolution. The body's ability to generate power, heal itself, process information, and maintain countless functions simultaneously represents one of nature's most impressive achievements. Understanding these aspects of human physiology not only satisfies our curiosity but also helps us appreciate the importance of maintaining our health and treating our bodies with the respect they deserve. As scientific research continues to advance, we undoubtedly will discover even more fascinating facts about the remarkable machine we inhabit every day.